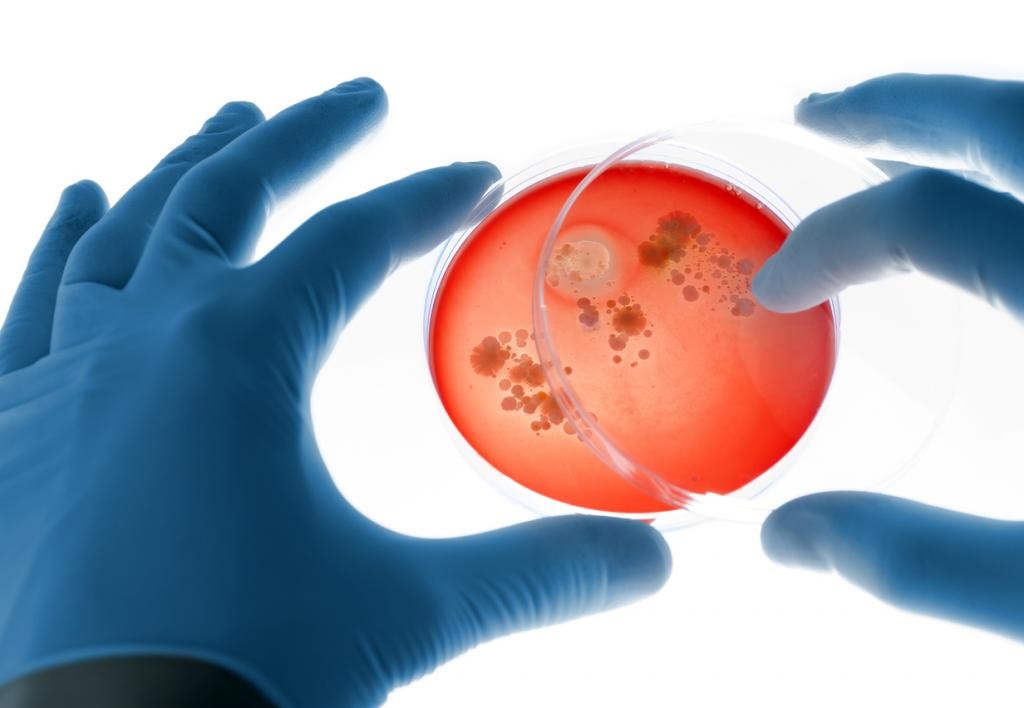

Description

Source: DownToEarth
Disclaimer: Copyright infringement not intended.
Context
- A collaborative study by scientists from the Indian Institute of Technology Madras (IIT-M) and NASA’s Jet Propulsion Laboratory (JPL) has unveiled significant findings regarding a multi-drug-resistant pathogen, Enterobacter bugandensis, aboard the International Space Station (ISS).
- This bacterium, notorious for causing hospital-acquired infections, poses a significant challenge both in space and on Earth.
Details
Key Findings
- Pathogen Characteristics:
- Enterobacter bugandensisis part of the ESKAPE group of pathogens, known for their resistance to multiple drugs and their prevalence in hospital-acquired infections.
- These pathogens are particularly resistant to third-generation cephalosporins and quinolones.
- Unique Environment of ISS:
- The ISS provides a unique setting with microgravity, heightened carbon dioxide levels, and increased radiation, which affect microbial dynamics.
- Researchers isolated 13 strains of bugandensisfrom various surfaces within the ISS, noting that these strains underwent accelerated mutations, making them genetically and functionally distinct from their Earth counterparts.
- Genomic and Functional Adaptations:
- Stress-induced genomic adaptations in the ISS strains bolster their resistance to antimicrobial treatments.
- The ISS strains displayed remarkable persistence and coexisted with other microorganisms, sometimes even aiding in their survival.

Enterobacter bugandensis
- Enterobacter bugandensisis a multi-drug-resistant bacterium known for causing hospital-acquired infections.
- It belongs to the ESKAPE group of pathogens, which are notorious for their ability to evade antibiotic treatments and contribute to significant morbidity and mortality in healthcare settings.
Classification and Characteristics
- Taxonomy:
- Kingdom: Bacteria
- Phylum: Proteobacteria
- Class: Gammaproteobacteria
- Morphology:
- Gram-negative, rod-shaped bacterium.
- Facultative anaerobe capable of thriving in both aerobic and anaerobic conditions.
Pathogenicity and Clinical Relevance
- Infections:
- Known to cause a variety of infections, particularly in healthcare settings, including urinary tract infections, respiratory infections, wound infections, and sepsis.
- Particularly problematic in immunocompromised patients and those with invasive devices such as catheters and ventilators.
- Antibiotic Resistance:
- Exhibits broad resistance to multiple antibiotics, including third-generation cephalosporins and quinolones.
- Part of the ESKAPE group, which includes other high-priority pathogens like Enterococcus faecium, Staphylococcus aureus, Klebsiella pneumoniae, Acinetobacter baumannii, and Pseudomonas aeruginosa.
Must read articles:
ISS
Sources:
DownToEarth
|
PRACTICE QUESTION
Q. Discuss the global implications of multi-drug-resistant pathogens, with a focus on challenges in treatment, prevention strategies, and the role of international cooperation in addressing this critical health issue. (250 Words)
|